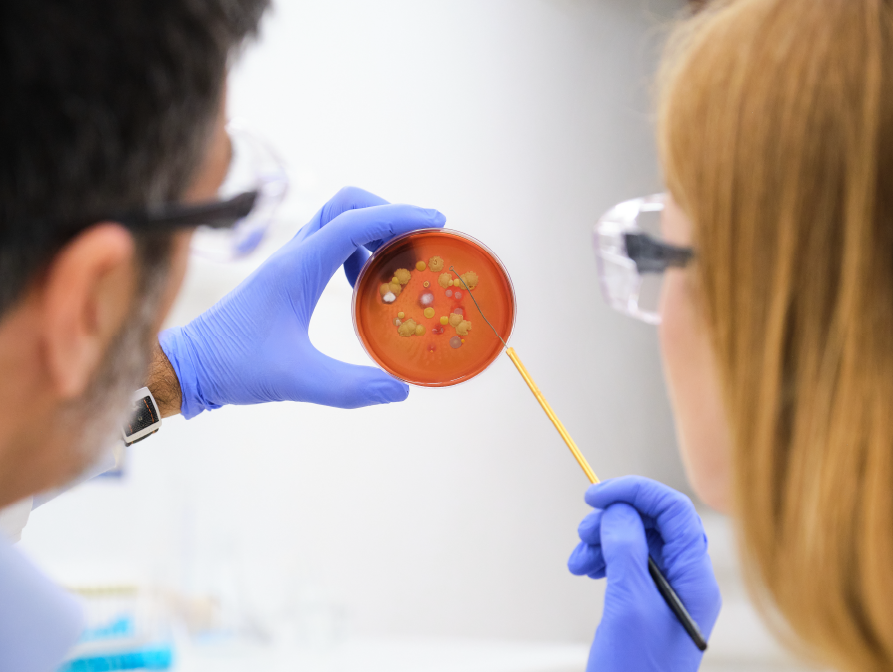

At Apex Cultures®, we specialize in premium brewing solutions, including high-quality yeast, nutrients, enzymes, finings and additives all designed to support exceptional fermentation and flavor development. Our brewing yeast is proudly produced in Sweden by a team with over 50 years of expertise in yeast production, processing, and packaging. Developed under stringent quality control measures, our products ensure consistent and healthy fermentations across a wide variety of beer styles. Through rigorous monitoring of yeast health, detailed characterization of fermentation performance, and vigilant observation of essential chemical and microbiological contaminants, we deliver dry yeast, nutrients, and enzymes that brewers can trust. Whether you're crafting at a small brewery or managing large-scale operations, Apex Cultures® is committed to empowering brewers worldwide with innovative solutions they can rely on.

Apex Cultures® offers a comprehensive product line crafted with an unwavering commitment to quality, backed by ISO 9001-certified quality control processes, and made with non-GMO ingredients. Our premium offerings include high-performance brewing yeast strains for lagers, ales, and specialty beverages like hard seltzer, sour beer, and cider. Each product undergoes rigorous testing and monitoring to ensure consistent fermentations, exceptional flavor development, and reliability in every batch. Alongside our yeast selection, we provide expertly formulated yeast nutrients and brewing enzymes to optimize fermentation and efficiency. With over 50 years of expertise and a steadfast dedication to excellence, Apex Cultures delivers products brewers can trust to create world-class, non-GMO beverages.
Apex Cultures® offers a comprehensive product line designed to meet the diverse needs of brewers worldwide. Our premium range includes high-performing brewing yeast strains for ales, lagers, and specialty beverages like hard seltzer, sour beer, and cider. Complementing our yeast selection, we provide expertly formulated yeast nutrients, advanced brewing enzymes, and performance-driven fining solutions such as BioClear and FlocuClear—designed to enhance clarity, improve stability, and optimize brewhouse efficiency from mash to package. Together, these solutions support optimal fermentation performance, flavor consistency, and streamlined production.
Backed by over 50 years of industry expertise and stringent quality control, every Apex Cultures® product is crafted to deliver reliable, repeatable results—empowering breweries of all sizes to create outstanding beverages with confidence and precision. We are proud to partner with LD Carlson Company as our exclusive U.S. distributor, expanding access to our premium brewing solutions. Together, we remain committed to advancing the craft of brewing through exceptional quality, technical innovation, and world-class service.


